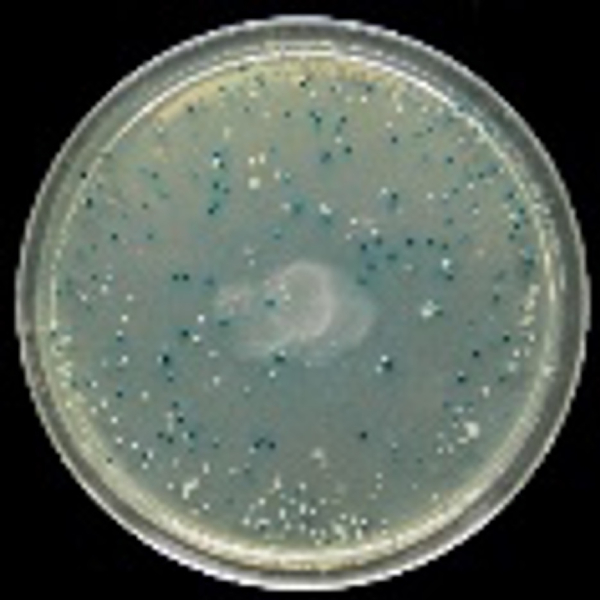

Реактивы для генной инженерии и молекулярной биологии ИПТГ и X-Gal – лучший выбор!
Компания Стар-лаб предлагает реактивы для генной инженерии и молекулярной биологии, в том числе индуктор lac-оперона ИПТГ и хромогенный субстрат X-Gal, используемые для проведения бело-голубого скрининга. Метод бело-голубой селекции – это колориметрическая система отбора рекомбинантных клонов, которая основана на изменении цвета бактериальных колоний в зависимости от наличия или отсутствия генно-инженерной вставки в плазмиде. Это простой и эффективный метод выявления рекомбинантных бактерий в экспериментах по клонированию.
Центральное место в этой технике занимает активность β-галактозидазы, фермента, кодируемого геном lacZ у E. coli, который метаболизирует лактозу с образованием глюкозы и галактозы. В активном состоянии он существует в виде тетрамера. Присутствие лактозы в окружающей среде запускает оперон lacZ в E. coli, что приводит к продукции фермента β-галактозидазы. Большинство плазмидных векторов несут короткий сегмент гена lacZα, который кодирует α-пептид, неактивный сегмент β-галактозидазы. Используемые в клонировании штаммы E. coli представляют собой компетентные клетки, содержащие делеционную мутацию lacZΔM15 и продуцирующие мутантную форму β-галактозидазы , неспособную образовывать тетрамер. Однако, в присутствии α-пептида эта мутантная форма белка может полностью вернуться в свое активное тетрамерное состояние. Восстановление функции мутантной β-галактозидазы с помощью α-пептида называется α-комплементацией.
Альтернативно, β-галактозидаза может гидролизовать другой субстрат, X-Gal, в результате чего образуется производное индиго синего цвета. X-gal, или 5-бром-4-хлор-3-индолил-бета-D-галактопиранозид — хромогенный субстрат для β-галактозидазы, образующий при гидролизе темно-синий продукт.

Процесс α-комплементации используется в качестве маркера рекомбинации. Клонирование чужеродного гена в вектор происходит внутрь гена β-галактозидазы (lacZ) в области MCS (мультиклональный сайт, полилинкер) (рис.1). В результате этого происходит разрыв кодирующей части гена lacZ и инактивация β-галактозидазы.

Для скрининга клонов, содержащих рекомбинантную ДНК, в чашку с агаром добавляют X-gal. Если образуется β-галактозидаза, X-gal гидролизуется с образованием нерастворимого синего пигмента. Поэтому колонии синего цвета образованы клетками, не содержащими вставку. Колонии, несущие рекомбинантную плазмидную ДНК, выглядят белыми из-за нарушения гена lacZ. Для проведения бело-голубого скрининга после трансформации вместе с X-Gal добавляют Изопропил-β-D-тиогалактопиранозид, или ИПТГ, который служит индуктором экспрессии гена lacZ ω.

Рис.1. Схематическое изображение бело-голубого скрининга.
1 – Рестрикция;
2 – лигирование;
3 - трансформация;
4 - скрининг на среде, содержащей X-gal и ИПТГ.
Информация для заказа:
ИПТГ и X-gal
|
949110.5 gm
|
|
|
хранение +2...+8°C, транспортировка +2...+8 °C
|
16 770
16 770 AMD
|
|
|
|||||
|
GC205011-1g
|
|
|
хранение +2...+8°C
|
8 252
8 252 AMD
|
|
|
|||||
|
R0392
|
|||||||||||
|
ИПТГ (Изопропил-β-D-1-тиогалактопиранозид) - высокостабильный аналог лактозы. Он инактивирует lac-репрессор и индуцирует синтез бета-галактозидазы, фермента, метаболизирующего лактозу. Используется как индуктор экспрессии генов, клонированных под контроль lac-оперона. Также используется совместно с X-Gal для бело-голубой селекции клонов. Рекомендуется приготовление стокового раствора в концентрации 100 мМ. Для бело-голубой селекции используется конечная концентрация 0.1 мМ. Условия хранения: +4оС |
|||||||||||
|
1140GR100
|
|
|
хранение -20°C
|
По запросу По запросу |
|
|
|||||
|
R0404
|
|
1 г
|
транспортировка -20°C
|
210 471
210 471 AMD
|
|
|
|||||
|
X-gal, или 5-бром-4-хлор-3-индолил-бета-D-галактопиранозид — хромогенный субстрат для фермента бета-галактозидазы. При расщеплении бета-галактозидазой от субстрата отщепляется индольная структура, которая спонтанно окисляется и выпадает в виде осадка синего цвета. Это свойство широко используется в молекулярной и клеточной биологии.
В первую очередь, X-gal применяется для анализа активности репортерного гена lacZ, кодирующего бета-галактозидазу, в клетках бактерий, дрожжей и животных. В растениях в качестве репортерного гена, маркером активности которого также является X-gal, используется ген GUS. Также X-gal используется совместно с конъюгатами гликозидаз в качестве реагента для вторичной детекции при иммуногистохимии и ELISA.Наконец, поскольку бета-галактозидаза сохраняет свою активность в фиксированных клетках и тканях, X-gal используется для детекции её активности. |
|||||||||||
|
998905.1 gm
|
|
|
хранение +2...+8°C
|
102 494
102 494 AMD
|
|
|
|||||
|
|
|||||||||||
Ферменты и вода для молекулярной биологии
|
3783.0050ду
|
|
50 мл
|
хранение -20°C, транспортировка +2...+8 °C
|
15 422
15 422 AMD
|
|
|
|||||
|
Стерильная вода, обработанная диэтилпирокарбонатом (ДЭПК), свободная от РНКаз и ДНКаз, предназначена для работы c ДНК и РНК, приготовления растворов для молекулярно-биологических работ, проведения различных молекулярно-биологических реакций. Условия хранения: комнатная температура. |
|||||||||||
|
3903.0020
|
|
|
хранение -20°C
|
25 920
25 920 AMD
|
|
|
|||||
|
3903.0080
|
|
|
хранение -20°C
|
56 920
56 920 AMD
|
|
|
|||||
|
3904.1000
|
|
|
хранение -20°C
|
278 381
278 381 AMD
|
|
|
|||||
|
3904.0100
|
|
|
хранение -20°C
|
64 878
64 878 AMD
|
|
|
|||||
|
3904.0200
|
|
|
хранение -20°C
|
109 097
109 097 AMD
|
|
|
|||||
|
3883.1000
|
|
|
хранение -20°C
|
121 752
121 752 AMD
|
|
|
|||||
|
3883.0250
|
|
|
хранение -20°C
|
33 770
33 770 AMD
|
|
|
|||||
|
3882.1000
|
|
|
хранение -20°C
|
59 098
59 098 AMD
|
|
|
|||||
|
3882.0250
|
|
|
хранение -20°C
|
22 291
22 291 AMD
|
|
|
|||||
|
|
|||||||||||
Среды для культивирования
|
Диаэм
|
|||||||||||||||||||||||||||
|
3139.0250
|
|||||||||||||||||||||||||||
|
|||||||||||||||||||||||||||
|
3136.0250
|
|||||||||||||||||||||||||||
|
|||||||||||||||||||||||||||
|
3137.0250
|
|||||||||||||||||||||||||||
|
|||||||||||||||||||||||||||
|
Диаэм
|
|||||||||||||||||||||||||||
|
3140.0250
|
|||||||||||||||||||||||||||
|
|||||||||||||||||||||||||||
|
3142.0250
|
|||||||||||||||||||||||||||
|
|||||||||||||||||||||||||||
|
3144.0250
|
|||||||||||||||||||||||||||
|
|||||||||||||||||||||||||||
|
3145.0250
|
|||||||||||||||||||||||||||
|
|||||||||||||||||||||||||||
|
Диаэм
|
|||||||||||||||||||||||||||
|
3133.0250
|
|||||||||||||||||||||||||||
|
|||||||||||||||||||||||||||
|
|
|||||||||||||||||||||||||||
Наборы для клонирования
|
C601-01
|
|
|
хранение -30...-15°C
|
112 648
112 648 AMD
|
|
|
|||||
|
C601-02
|
|
|
хранение -30...-15°C
|
202 674
202 674 AMD
|
|
|
|||||
|
C112-02
|
|
|
хранение -30...-15°C
|
202 674
202 674 AMD
|
|
|
|||||
|
C113-01
|
|
|
хранение -30...-15°C
|
53 644
53 644 AMD
|
|
|
|||||
|
C113-02
|
|
|
хранение -30...-15°C
|
111 415
111 415 AMD
|
|
|
|||||
|
C115-01
|
|
|
хранение -30...-15°C
|
150 046
150 046 AMD
|
|
|
|||||
|
C115-02
|
|
|
хранение -30...-15°C
|
243 545
243 545 AMD
|
|
|
|||||
|
|
|||||||||||
Реактивы и наборы для выделения, очистки, элюции, наборы и экстра миксы для ПЦР
|
512050
|
|
5 мл
|
По запросу По запросу |
|
|
|||||||||||||||||||||||||
|
3316.0050
|
||||||||||||||||||||||||||||||
|
Набор предназначен для выделения до 25 мкг плазмидной ДНК длиной до 20 т.п.н. из 3-5 мл бактериальной культуры. Очистка ДНК на колонках diaGene происходит за счёт избирательного связывания ДНК с сорбентом в присутствии хаотропной соли с последующей отмывкой связанной ДНК от примесей и заканчивается элюцией чистого препарата ДНК.
Выход ДНК зависит от ряда факторов: копийности плазмиды, условий роста, объёма культуры и т.д. Не рекомендуется использовать для выделения плазмид длиной свыше 50 тысяч пар нуклеотидов, а также для получения препарата плазмидной ДНК для трансфекции эукариотических клеток. Набор diaGene для выделения плазмидной ДНК из бактерий, diaGene, инструкция по применению, Стар-лаб, русск., 2 стр. |
||||||||||||||||||||||||||||||
|
3317.0050
|
||||||||||||||||||||||||||||||
|
Набор предназначен для выделения тотальной РНК из культуры животных клеток. Выделение РНК начинается с лизиса клеток, при этом ядра, содержащие геномную ДНК, остаются интактными. Очистка нуклеиновой кислоты происходит за счёт связывания РНК с сорбентом колонок diaGene. Связанная РНК отмывается от примесей и элюируется в виде чистого препарата. Выход РНК зависит от типа и количества клеток, поэтому надо учитывать, что ёмкость колонок — до 20 мкг.
Набор diaGene для выделения РНК из культур клеток, Стар-лаб, русск., 4 стр. |
||||||||||||||||||||||||||||||
|
1957.0500
|
||||||||||||||||||||||||||||||
|
Набор реактивов для ПЦР с Taq-ДНК-полимеразой Hot Start содержит рекомбинантную HS-Taq ДНК-полимеразу и растворы всех необходимых компонентов для проведения стандартной ПЦР c "горячим" стартом (за исключением матрицы ДНК и праймеров). В состав набора входят: раствор HS-Taq ДНК-полимеразы (5 ед. акт./мкл), 5× ПЦР буфер, 50 мМ MgCl2, 50× смесь dNTP и 6× буфер для нанесения на гель. Все реагенты высокого качества и оптимизированы для проведения ПЦР.
HS-Taq ДНК-полимераза представляет собой рекомбинантную Taq ДНК-полимеразу, инактивированную специфическими моноклональными антителами. HS-Taq ДНК-полимераза неактивна при температуре до +70 °С. Это позволяет избежать образования неспецифических продуктов и праймер-димеров при низкой температуре на стадии смешивания компонентов ПЦР-смеси. Активация осуществляется на первом цикле ПЦР путём 5-минутной инкубации при +95 °С. Рекомбинантная Taq ДНК-полимераза обладает 5´-3´ ДНК-зависимой полимеразной активностью и 5´-3´ экзонуклеазной активностью нативной Taq ДНК-полимеразы из Thermus aquaticus. Скорость продвижения Taq ДНК-полимеразы зависит от сложности ДНК-матрицы и составляет примерно 1 т.п.н./мин. Рекомбинантная HS-Taq ДНК-полимераза идеально подходит для стандартной ПЦР с матрицы до 5 т.п.н. и обладает способностью присоединять адениновый остаток к 3’-концу синтезируемой цепи ДНК, поэтому ПЦР-фрагменты пригодны для ТА-клонирования. 5× ПЦР-буфер оптимизирован для проведения эффективной и воспроизводимой ПЦР (не содержит MgCl2). В состав буфера входят добавки, повышающие время полужизни и процессивность HS-Taq ДНК-полимеразы за счет повышения её стабильности во время ПЦР. Буфер химически стабилен, инертен и не меняет оптимальной температуры отжига праймеров или характеристики плавления матрицы. Входящие в набор 50 мМ раствор MgCl2 и 50× смесь dNTP позволяют легко оптимизировать реакционную смесь под конкретную систему «матрица-праймеры», а 6× Буфер для нанесения на гель облегчает пробоподготовку для электрофореза ПЦР-продуктов и контроль над ходом электрофореза. Состав набора
* За единицу активности принимали количество фермента, катализирующее включение 10 нмоль dNTP в кислотонерастворимый продукт за 30 мин при 74 °С.Условия реакции:50 мМ Трис-HCl, pH 9.0 (при 25 °С), 50 мМ NaCl, 10 мМ MgCl2, 200 мM dATP, 200 мM dCTP, 200 мM dGTP, 50 мM [3H] dTTP, 0.25 мг/мл активированной ДНК из тимуса теленка. Буфер для хранения HS-Taq ДНК-полимеразы: 50 мМ Трис-HCl, pH 8.0 (при 25 °С), 50 мМ NaCl, 0,1 мМ ЭДТА, 1мМ дитиотреитол, 50% (v/v) глицерин и 1% (v/v) Тритон Х-100. 5× ПЦР-буфер: 50 мM Трис-НCl, рН 8.5 (при 25 °С), 250 мM KCl, 0.5% (v/v) Tween 20, стабилизаторы Taq ДНК-полимеразы. Область применения:
Ингибиторы: ионные детергенты (дезоксихолат натрия, саркозил и додецилсульфат натрия (SDS) в концентрациях выше, чем 0,06, 0,02 и 0,01%, соответственно). Инактивируется экстракцией смесью фенол/хлороформ. Хранение и транспортировка: при -20°С; не более 50 циклов замораживания-размораживания. Срок хранения: при соблюдении условий хранения и транспортировки 1 год. 1957_ Набор реактивов для ПЦР с Taq-полимеразой Hot Start, инструкция, Стар-лаб, русск., 4 стр. |
||||||||||||||||||||||||||||||
|
1958.0500
|
||||||||||||||||||||||||||||||
|
Набор реактивов для ПЦР с Taq-полимеразой Hot Start (+MgCl2) содержит рекомбинантную HS-Taq ДНК-полимеразу и растворы всех необходимых компонентов для проведения стандартной ПЦР c “горячим” стартом (за исключением матрицы ДНК и праймеров). ПЦР-буфер, входящий в состав набора, уже содержит MgCl2
в концентрации 10 мМ, достаточной для постановки большинства рутинных ПЦР.
HS-Taq ДНК-полимераза представляет собой рекомбинантную Taq ДНК-полимеразу, инактивированную специфическими моноклональными антителами. HS-Taq ДНК-полимераза не активна при температуре до +70 °С. Это позволяет избежать образования неспецифических продуктов и праймер-димеров при низкой температуре на стадии смешивания компонентов ПЦР-смеси. Активация осуществляется на первом цикле ПЦР путём инкубации в течение 5 мин при +95 °С. Рекомбинантная Taq ДНК-полимераза обладает 5´-3´ ДНК-зависимой полимеразной активностью и 5’-3’ экзонуклеазной активностью нативной Taq ДНК-полимеразы из Thermus aquaticus. Скорость продвижения Taq ДНК-полимеразы зависит от сложности ДНК-матрицы и составляет примерно 1 т.п.н./мин. HS-Taq ДНК-полимераза идеально подходит для стандартной ПЦР с матрицы до 5 т.п.н.; она обладает способностью присоединять адениновый остаток к 3’-концу синтезируемой цепи, поэтому продукты ПЦР могут использоваться для ТА-клонирования. 5× ПЦР-буфер (+MgCl2) оптимизирован для проведения эффективной и воспроизводимой ПЦР. В состав буфера входят MgCl2 (10 мМ) и добавки, повышающие время полужизни и процессивность HS-Taq ДНК-полимеразы за счет повышения её стабильности во время ПЦР. Буфер химически стабилен, инертен и не меняет оптимальной температуры отжига праймеров или характеристики плавления матрицы. Входящие в набор 50 мМ раствор MgCl2 и 50× смесь dNTP позволяют легко оптимизировать реакционную смесь под конкретную систему «матрица-праймеры», а 6× Буфер для нанесения на гель облегчает пробоподготовку для электрофореза ПЦР-продуктов и контроль над ходом электрофореза. Состав набора
* За единицу активности принимали количество фермента, катализирующее включение 10 нмоль dNTP в кислотонерастворимый продукт за 30 мин при 74 °С. Условия реакции: 50 мМ Трис-HCl, pH 9.0 (при 25 °С), 50 мМ NaCl, 10 мМ MgCl2, 200 мM dATP, 200 мM dCTP, 200 мM dGTP, 50 мM [3H] dTTP, 0,25 мг/мл активированной ДНК из тимуса теленка. Буфер для хранения HS-Taq ДНК-полимеразы: 50 мМ Трис-HCl, pH 8.0 (при 25 °С), 50 мМ NaCl, 0.1 мМ ЭДТА, 1мМ дитиотреитол, 50% (v/v) глицерин и 1% (v/v) Тритон Х-100. 5× ПЦР буфер (+MgCl2): 50 мM Трис-НCl, рН 8.5 (при 25 °С), 250 мM KCl, 10 мМ MgCl2, 0.5% (v/v) Tween 20, стабилизаторы Taq ДНК-полимеразы. Область применения: ПЦР с “горячим” стартом. Высокопроизводительная ПЦР. Обычная ПЦР с высокой воспроизводимостью. Наработка ПЦР-продуктов для ТА клонирования. Вторая стадия ОТ-ПЦР. Ограничения к использованию:
Ингибиторы: ионные детергенты (дезоксихолат натрия, саркозил и додецилсульфат натрия (SDS) в концентрациях выше, чем 0,06, 0,02 и 0,01%, соответственно). Инактивируется экстракцией смесью фенол/хлороформ. Хранение и транспортировка: при -20 °С; не более 50 циклов замораживания-размораживания. Срок хранения: при соблюдении условий хранения и транспортировки 1 год. 1958_ Набор реактивов для ПЦР с Taq-полимеразой и 10 мМ MgCl2, инструкция, Стар-лаб, русск., 4 стр. |
||||||||||||||||||||||||||||||
|
3326.0050
|
||||||||||||||||||||||||||||||
|
Набор предназначен для элюции и очистки фрагментов ДНК из легкоплавкого агарозного геля после электрофоретического разделения. С помощью набора можно элюировать ДНК из ТАЕ- или ТВЕ-геля, процесс прост и занимает не более 15-20 минут. После отмывки от примесей чистый препарат ДНК элюируется с колонки.
Полученный препарат ДНК может использоваться для рестриктазного расщепления, лигирования, секвенирования и др. Ёмкость колонки diaGene составляет до 25 мкг ДНК. Буфер для сорбции М содержит в своем составе индикатор кислотности. Эффективность сорбции ДНК зависит от рН (связывание ДНК с сорбентом происходит при рН < 7,5). При оптимальном для сорбции рН индикатор имеет желтый цвет. Если после добавления к образцу
буфера М цвет индикатора отличается от желтого, к смеси необходимо добавить 10 мкл 3М ацетата Na (pH 5,0).
Набор для элюции ДНК из агарозного геля, diaGene, инструкция по применению, Стар-лаб, русск., 2 стр. |
||||||||||||||||||||||||||||||
|
3790.0100
|
||||||||||||||||||||||||||||||
|
3789.0100
|
||||||||||||||||||||||||||||||
|
Реагент RIzol для выделения суммарной РНК из различных биологических образцов — это готовый к использованию реагент для выделения высококачественной суммарной РНК из образцов человеческого, животного, растительного, дрожжевого, бактериального и вирусного происхождения. Под действием реагента RIzol происходит гомогенизация биологического образца и лизис клеток, не нарушая целостность РНК за счет ингибирования действия РНКаз. Процедура выделения РНК занимает не более часа. Выделение ДНК и белков с использованием реагента RIzol — менее трех часов. Выделенная РНК может быть использована для синтеза кДНК, ОT-ПЦР, трансляции in vitro и др. Особенности реагента RIzolРеагент RIzol имеет следующие особенности:
Условия хранения и перевозки: при 20 °С в темном месте. |
||||||||||||||||||||||||||||||
|
R201-02
|
|
|
хранение -20°C
|
81 182
81 182 AMD
|
|
|
||||||||||||||||||||||||
|
R201-01
|
|
|
хранение -20°C
|
17 356
17 356 AMD
|
|
|
||||||||||||||||||||||||
|
R302-01
|
|
|
хранение -20°C
|
101 337
101 337 AMD
|
|
|
||||||||||||||||||||||||
|
R021-01
|
|
|
хранение -20°C
|
40 871
40 871 AMD
|
|
|
||||||||||||||||||||||||
|
3878.0010
|
|
|
хранение -20°C
|
52 877
52 877 AMD
|
|
|
||||||||||||||||||||||||
|
3878.0100
|
|
|
хранение -20°C
|
По запросу По запросу |
|
|
||||||||||||||||||||||||
|
3878.0050
|
|
|
хранение -20°C
|
По запросу По запросу |
|
|
||||||||||||||||||||||||
|
3880.0010
|
|
|
хранение -20°C
|
60 446
60 446 AMD
|
|
|
||||||||||||||||||||||||
|
3880.0100
|
|
|
хранение -20°C
|
По запросу По запросу |
|
|
||||||||||||||||||||||||
|
3880.0050
|
|
|
хранение -20°C
|
По запросу По запросу |
|
|
||||||||||||||||||||||||
|
3879.0010
|
|
|
хранение -20°C
|
55 987
55 987 AMD
|
|
|
||||||||||||||||||||||||
|
3879.0100
|
|
|
хранение -20°C
|
328 148
328 148 AMD
|
|
|
||||||||||||||||||||||||
|
3879.0050
|
|
|
хранение -20°C
|
По запросу По запросу |
|
|
||||||||||||||||||||||||
|
3327.0100
|
||||||||||||||||||||||||||||||
|
Применение: получение длинных фрагментов до 25 000 п.н., получение продуктов для ТА-клонирования, амплификация GC-богатых и сложных матриц. Из-за содержания инертного красителя смесь не рекомендуется использовать для ПЦР в реальном времени и других приложений, требующих измерения флуоресценции; для таких приложений необходимо использовать смесь qPCR (2х) и qPCR SYBR Blue (2х).
|
||||||||||||||||||||||||||||||
|
|
||||||||||||||||||||||||||||||
А также:
|
7000
|
|
|
117 459
117 459 AMD
|
|
|
||||||
|
Горелка Бунзена газовая DIN 30665 для природного газа — № 7000: Горелки Бунзена, Теклю и Мекера предназначены для работы как с природным газом (метан), так и со сжиженным газом (пропан, бутан). Горелки Бунзена и Теклю применяются в тех случаях, когда необходимо узкое и высокое пламя: для нагрева небольших сосудов, колб, пробирок и т.п. изделий, а также материалов, соизмеримых с размерами факела. Недостаток горелок Теклю и Бунзена — проскоки пламени. Горелка Мекера создает равномерное пламя с постоянной интенсивностью нагрева и не имеет проскока пламени. Перфорированная решетка в верхней части горелки создает большое по площади пламя с высокой температурой, состоящее из множества отдельных факелов. Горелки Мекера применяются в случаях, когда необходимо широкое по размерам пламя с высокой температурой, например, для плавки, сплавливания и прокаливания различных веществ, а также нагрева жидких реагентов. Для плавного регулирования тепловой мощности (потока газа) в конструкции горелок предусмотрен либо игольчатый, либо откидной клапан. Скачать каталоги брошюры: |
|||||||||||
|
7010
|
|
|
117 459
117 459 AMD
|
|
|
||||||
|
Горелка Бунзена газовая DIN 30665 для пропана/бутана — № 7000: Горелки Бунзена, Теклю и Мекера предназначены для работы как с природным газом (метан), так и со сжиженным газом (пропан, бутан). Горелки Бунзена и Теклю применяются в тех случаях, когда необходимо узкое и высокое пламя: для нагрева небольших сосудов, колб, пробирок и т.п. изделий, а также материалов, соизмеримых с размерами факела. Недостаток горелок Теклю и Бунзена — проскоки пламени. Горелка Мекера создает равномерное пламя с постоянной интенсивностью нагрева и не имеет проскока пламени. Перфорированная решетка в верхней части горелки создает большое по площади пламя с высокой температурой, состоящее из множества отдельных факелов. Горелки Мекера применяются в случаях, когда необходимо широкое по размерам пламя с высокой температурой, например, для плавки, сплавливания и прокаливания различных веществ, а также нагрева жидких реагентов. Для плавного регулирования тепловой мощности (потока газа) в конструкции горелок предусмотрен либо игольчатый, либо откидной клапан. Скачать каталоги брошюры: |
|||||||||||
|
7200
|
|
|
50 886
50 886 AMD
|
|
|
||||||
Характеристики горелки спиртовой № 7200: |
|||||||||||
|
2821
|
|
|
6 897
6 897 AMD
|
|
|
||||||
|
1813
|
|
|
11 690
11 690 AMD
|
|
|
||||||
|
10000832
|
|
|
Регистрационное удостоверение на медицинское изделие
Росздравнадзора
|
1 665
1 665 AMD
|
|
|
|||||
|
3539
|
|
|
4 562
4 562 AMD
|
|
|
||||||
|
|
|||||||||||
|
3541
|
|
|
4 562
4 562 AMD
|
|
|
||||||
|
|
|||||||||||
|
3217
|
|
|
4 562
4 562 AMD
|
|
|
||||||
|
|
|||||||||||
|
2230
|
|
|
19 181
19 181 AMD
|
|
|
||||||
|
3315
|
|
|
Регистрационное удостоверение на медицинское изделие
Росздравнадзора
|
24 883
24 883 AMD
|
|
|
|||||
|
|||||||||||
|
3362152
|
|
|
27 845
27 845 AMD
|
|
|
||||||
|
Диаметр, мм - 4; Длина, мм - 185; Ширина, мм - 57. |
|||||||||||
|
65-1010
|
|
|
18 505
18 505 AMD
|
|
|
||||||
|
|||||||||||
|
3362162
|
|
|
21 745
21 745 AMD
|
|
|
||||||
|
Диаметр, мм - 5; Длина, мм - 145; Ширина, мм - 50. |
|||||||||||
|
|
|||||||||||
См. также:
Антибиотики, буферы, добавки, ферменты, факторы роста для культуральных сред
Выделение и очистка нуклеиновых кислот
Молекулярное клонирование, модификация нуклеиновых кислот
Наконечники для пипеток автоматических
Петли, иглы микробиологические
Пробирки и бутыли для центрифугирования
Среды для молекулярной биологии
Ниже вы можете задать вопрос или оставить запрос в свободной форме:
Все поля со звездочкой (*) обязательны для заполнения
Данное действие необратимо.
чтобы сделать работу на сайте еще удобнее!
С помощью личного кабинета Вы сможете:
- моментально получать счета на оформленные заказы;
- отслеживать статусы выполнения заказа по оплате, отгрузке, наличию товаров на складе;
- вести историю заказов, повторять заказы полностью или частично;
- выбирать персонального менеджера;
- формировать списки избранного среди товаров, справочных материалов и видео;
- делать заказ со страницы избранных товаров;
- экономить время при заполнении форм заказа по каталогам и регистрации на мероприятия.



















































